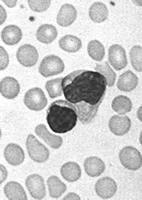
Bkab7.jpg

传染性单核细胞增多症
传染性单核细胞增多症(Infectious mononucleosis)是由EB病毒(EBV)所致的急性自限性传染病。其临床特征为发热,咽喉炎,淋巴结肿大,外周血淋巴细胞显著增多并出现异常淋巴细胞,嗜异性凝集试验阳性,感染后体内出现抗EBV抗体。
病原学[编辑 | 编辑源代码]
EBV属疱疹病毒群。1964年由Epstein、Barr等从非洲恶性淋巴瘤的细胞培养中首先发现。病毒呈球形,直径约180nm,衣壳表面附有脂蛋白包膜,核心为双股DNA。
本病毒对生长要求极为特殊,故病毒分离较困难。但在培养的淋巴细胞中用免疫荧光或电镜法可检出本病毒。EBV有嗜B细胞特性并可作为其致裂原,使B淋巴细胞转为淋巴母细胞。
EBV有五种抗原成分,即病毒衣壳抗原(VcA)、膜抗原(MA)、早期抗原(EA)、补体结合抗原(可溶性抗原S)和核抗原(EBNA)。各种抗原均能产生相应的抗体。
流行病学[编辑 | 编辑源代码]
(一)传染源 带毒者及病人为本病的传染源。健康人群中带毒率约为15%。
(二)传播途径 80%以上患者鼻咽部有EB病毒存在,恢复后15~20%可长期咽部带病毒。经口鼻密切接触为主要传播途径,也可经飞沫及输血传播。
(三)易感人群人群普遍易感,但儿童及青少年患者更多见。6岁以下幼儿患本病时大多表现为隐性或轻型发病。15岁以上感染则多呈典型发病。病后可获持久免疫,第二次发病不常见。
发病机理[编辑 | 编辑源代码]
其发病原理尚未完全阐明。病毒进入口腔先在咽部的淋巴组织内进行复制,继而侵入血循环而致病毒血症,并进一步累及淋巴系统的各组织和脏器。因B细胞表面具EB病毒的受体,故先受累,导致B细胞抗原性改变,继而引起T细胞的强烈反应,后者可直接对抗被EB病毒感染的B细胞。周围血中的异常淋巴细胞主要是T细胞。
病理改变[编辑 | 编辑源代码]
对本病的病理变化尚了解不多。其基本的病毒特征是淋巴组织的良性增生。淋巴结肿大但并不化脓,肝、脾、心肌、肾、肾上腺、肺、中枢神经系统均可受累,主要为异常的多形性淋巴细胞侵润。
临床表现[编辑 | 编辑源代码]
潜伏期5~15天,一般为9~11天。起病急缓不一。约40%患者有前驱症状,历时4~5天,如乏力、头痛、纳差、恶心、稀便、畏寒等,本病的症状虽多样化,但大多数可出现较典型的症状。
(一)发热 高低不一,多在38~40℃之间。热型不定。热程自数日至数周,甚至数月。可伴有寒战和多汗。中毒症状多不严重。
(二)淋巴结肿大 见于70%的患者。以颈淋巴结肿大最为常见,腋下及腹股沟部次之。直径1~4cm,质地中等硬,分散,无明显压痛,不化脓、双侧不对称等为其特点。消退需数周至数月。肠系膜淋巴结肿大引起腹痛及压痛。
(三)咽痛 虽仅有半数患者主诉咽痛,但大多数病例可见咽部充血,少数患者咽部有溃疡及伪膜形成,可见出血点。齿龈也可肿胀或有溃疡。喉和气管的水肿和阻塞少见。
(四)肝脾肿大 仅10%患者出现肝肿大,肝功能异常者则可达2/3。少数患者可出现黄疸,但转为慢性和出现肝功能衰竭少见。50%以上患者有轻度脾肿大,偶可发生脾破裂。检查时应轻按以防脾破裂。
(五)皮疹 约10%左右的病例在病程1~2周出现多形性皮疹,为淡红色斑丘疹,亦可有麻疹样、猩红热样、荨麻疹样皮疹,多见于躯干部,一周内隐退,无脱屑。
(六)神经系统症状 见于少数严重的病例。可表现为无菌性脑膜炎,脑炎及周围神经根炎等。90%以上可恢复。
病程多为1~3周,少数可迁延数月。偶有复发,复发时病程短,病情轻。本病预后良好,病死率仅为1~2%,多系严重并发症所致。
辅助检查[编辑 | 编辑源代码]
实验室检查[编辑 | 编辑源代码]
1.血象 病初起时白细胞计数可以正常。发病后10~12天白细胞总数常有升高,高者可达3万~6万/mm3,第3周恢复正常。在发病的第1~21天可出现异常淋巴细胞(10%~20%或更多),依其细胞形态可分为泡沫型、不规则型、幼稚型等三型。这种异常细胞可能起源于T细胞,亦可见于其他病毒性疾病,如病毒性肝炎、流行性出血热、水痘、腮腺炎等,但其百分比一般低于10%。血小板计数可减少,极个别患者有粒细胞缺乏或淋巴细胞减少,可能与人体异常免疫反应有关。
2.骨髓象 缺乏诊断意义,但可除外其他疾病如血液病等。可有异常淋巴细胞出现(有认为可能为周围血液稀释所致)。中性粒细胞核左移,网状细胞可能增生。
3.嗜异性凝集试验 嗜异性凝集试验的阳性率达80%~90%,其原理是病人血清中常含有属于IgM啫异性抗体,可和绵羊红细胞或马红细胞凝集。抗体在体内持续的时间平均为2~5个月。较晚出现啫异性抗体者常常恢复较慢。少数病例(约10%)的嗜异性凝集试验始终阴性,大多属轻型,尤以儿童患者为多。
正常人、血清病患者以及少数患淋巴网状细胞瘤、单核细胞白血病、结核病等患者,其嗜异性凝集试验也可呈阳性结果(除血清病外,抗体效价均较低),但可用豚鼠肾和牛红细胞吸收试验加以鉴别。正常人和上述各种患者(血清病患者除外),血中嗜异性抗体可被豚鼠肾完全吸收或被牛红细胞部分吸收,而本病患者血中嗜异性抗体可被豚鼠肾部分吸收和牛红细胞完全吸收,而血清病患者血中抗体可被两者完全吸收。嗜异性凝集素效价从1∶50~1∶224均具有临床价值,一般认为其效价在1∶80以上具诊断价值。若逐周测定效价上升4倍以上,则意义更大。近年来采用玻片凝集法,用马红细胞代替绵羊红细胞,出结果较试管法快,比较灵敏。
4.EB病毒抗体测定 人体受EB病毒感染后,可以产生膜壳抗体、抗膜抗体、早期抗体、中和抗体、补体结合抗体、病毒相关核抗体等,各种抗体出现的时间与意义详见表11-15。
5.其他 EB病毒培养很少用于临床。测定血清中牛红细胞溶血素具诊断价值(效价在1∶400以上)。本病急性期尚可测到自身抗体,如抗i抗体(抗原i仅有于胎儿细胞内)、抗核抗体等。抗i冷凝集效价高时可致自身溶血性贫血。
诊断[编辑 | 编辑源代码]
散发病例易被忽视,诊断以临床症状、典型血象以及阳性嗜异性凝集试验为主要依据,尤以后二者较为重要,当出现流行时,流行病学资料有重大参考价值。
在开展血清学检查有困难时,根据血象结合临床也可作出诊断。临床表现虽以高热、咽峡炎、颈淋巴结肿大等比较常见,但并非必有。血清谷丙转氨酶在病程中大多升高,即使无黄疸者亦然,值得重视。典型血象及嗜异性凝集试验在病程的第2天即有改变或呈阳性,但显著变化一般见于第1~2周间,嗜异性凝集试验甚或在数月后始升达有意义的水平,故必须强调多次重复检查的重要性,1~2次阴性结果不能否定诊断。
传染性单核细胞增多症诊断标准[编辑 | 编辑源代码]
1.临床表现: ①发热;②咽炎;③淋巴结肿大;④肝脾肿大;⑤ 皮疹。
2.实验室检查:①淋巴细胞比例增多,异型淋巴细胞超过10%;②嗜异凝集试验阳性;③抗EB 病毒抗体VCA-IgM 阳性。
3.除外传单综合征 周围血中出现异型淋巴细胞,但嗜异凝集试验阴性。具备上述“1”中任何3 项,“2”中任何2 项,再加“3”可确诊。
鉴别诊断[编辑 | 编辑源代码]
巨细胞病毒病的临床表现酷似本病,该病肝、脾肿大是由于病毒对靶器官细胞的作用所致,传染性单核细胞增多症则与淋巴细胞增殖有关。巨细胞病毒病中咽痛和颈淋巴结肿大较少见,血清中无嗜异性凝集素及EB病毒抗体,确诊有赖于病毒分离及特异性抗体测定。本病也需与急性淋巴细胞性白血病相鉴别,骨髓细胞学检查有确诊价值。儿童中本病尚需与急性感染性淋巴细胞增多症鉴别,后者多见于幼儿,大多有上呼吸道症状,淋巴结肿大少见,无脾肿大;白细胞总数增多,主要为成熟淋巴细胞,异常血象可维持4~5周;嗜异性凝集试验阴性,血清中无EB病毒抗体出现。此外本病尚应与甲型病毒性肝炎和链球菌所致的渗出性扁桃体炎鉴别。
并发症[编辑 | 编辑源代码]
(一)呼吸系统 约30%患者可并发咽部细菌感染。5%左右患者可出现间质性肺炎。
(二)泌尿系统并发症 部分患者可出现水肿、蛋白尿、尿中管型及血尿素氮增高等类似肾炎的变化,病变多为可逆性。
(三)心血管系统并发症 并发心肌炎者约占6%,心电图示T波倒置、低平及P-R间期延长。
(四)神经系统并发症 可出现脑膜炎、脑膜脑炎、周围神经病变,发生率约为1%。
治疗[编辑 | 编辑源代码]
本病无特异性治疗,以对症治疗为主,患者大多能自愈。当并发细菌感染时,如咽部、扁桃体的β-溶血性链球菌感染可选用青霉素G、红霉素等抗生素,有人认为使用甲硝唑(灭滴灵)或氯林可霉素也有一定效果。
肾上腺皮质激素可用于重症患者,如咽部、喉头有严重水肿,出现神经系统并发症、血小板减少性紫癜、心肌炎、心包炎等,可改善症状,消除炎症。但一般病例不宜采用。
1.西医药治疗
(1)高热病人酌情补液。
2.中医药治疗
(1)发热期:恶寒商热,头身疼痛,呕吐腹泻,舌红苔黄腻,脉浮数或濡数。治法:解表清气,化湿清热。
(2)出疹期及出血:高热烦渴,斑疹外发,皮肤淤斑淤点,便血,呕叶腹痛等,舌红苔黄腻,脉滑数。治法:清热泻火,凉血解毒。
(3)休克期:面白肢冷,烦躁不安,体温下降,血压下降,脉细弱。治法:益气固脱。
(4)恢复期:倦怠无力,食欲不振,少气懒言,舌淡,脉细。治法:健脾和胃,益气养阴。
预后[编辑 | 编辑源代码]
本病预后大多良好。病程一般为1~2周,但可有复发。部分患者低热、淋巴结肿大、乏力、病后软弱可持续数周或数月。极个别者病程迁延达数年之久。本病病死率为1%~2%,死因为脾破裂、脑膜炎、心肌炎等。有先天性免疫缺陷者感染本病后,病情迅速恶化而死亡。本病与单核巨噬细胞系统恶性病变是两种迥然不同的疾病。虽EB病毒亦可见于淋巴瘤患者,但本病不会转化为淋巴瘤。
预防[编辑 | 编辑源代码]
目前尚无有效预防措施。急性期患者应进行呼吸道隔离。其呼吸道分泌物及痰杯应用漂白粉或煮沸消毒。因病毒血症可长达数月,故病后至少6个月不能参加献血。疫苗尚在研制中。
传染性单核细胞增多症的注意事项[编辑 | 编辑源代码]
1、注意观察体温变化及伴随的症状,体温超过38.5度应给予物理和药物降温。
2、发病初期应卧床休息2-3周,减少机体耗氧量,避免心肌受累。
3、饮食应给予清淡、易消化、高蛋白、高维生素的流食或半流食,少食干硬、酸性、辛辣食物,保证供给充足的水份,每天饮水量大约是少儿为1000-1500毫升、年长儿为1500-2000毫升。
4、皮肤的护理:注意保持皮肤清洁,每天用温水清洗皮肤,及时更换衣服,衣服应质地柔软、清洁干燥,避免刺激皮肤。保持手的清洁更重要,应剪短指甲,勿搔抓皮肤,防止皮肤破溃感染。
5、肝脾的护理:肝大、转氨酶高时可口服维生素c及肝太乐以保护肝脏。此病不会引起慢性肝炎。脾大时应避免剧烈运动(特别是在发病的第二周),以免发生外伤引起脾破裂。
6、淋巴结肿大的要注意定期复查血象,因淋巴结消退比较慢,可达数月之久。如发现颈部淋巴结肿痛、体温升高等情况,及时去医院就诊。
参看[编辑 | 编辑源代码]
| |||||||||||||||||
| ||||||||||||||||||||||||||||||||||||||